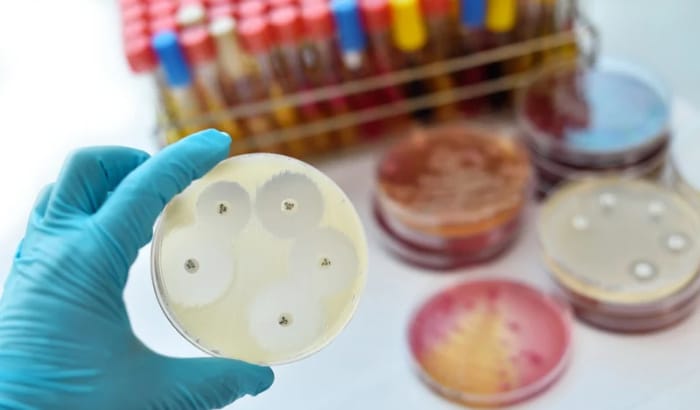

Thyme Essential Oil
Chemical Free
Cruelty Free
100% Natural
Paraben Free
Guarantee Safe Checkout

Thyme Essential Oil
Thyme Essential Oil
Thyme Essential Oil is a potent and versatile oil obtained through the steam distillation of the foliage and blossoms of the thyme plant. Rich in active compounds like thymol and carvacrol, it possesses remarkable antimicrobial, antifungal, and antioxidant properties, making it a valuable natural solution in various fields. Traditionally, thyme essential oil has been used in herbal medicine to support immunity, respiratory health, and overall wellness.
Its therapeutic potential extends to modern aromatherapy, where its warm, herbaceous scent promotes relaxation and uplifts the mood while also easing congestion and breathing discomfort. Beyond wellness, thyme essential oil has a notable role in perfumery, soap making, and personal care formulations, adding depth and freshness to fragrances and enhancing skincare products with its cleansing and healing effects. Owing to its effectiveness, affordability, and wide range of applications, thyme essential oil remains an indispensable ingredient in natural therapies, cosmetic products, and even industrial uses, offering a trusted, holistic alternative for health and well-being.
Product Specifications
Packaging Sizes